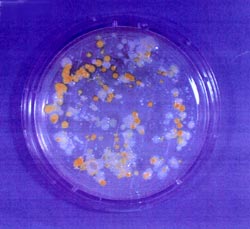

水系切削油剤の防錆・防食対策
液がいつまでも透明であることを特徴としたクリアータイプと称する油剤が市販されています。このタイプは、油分を含まず〈ノンミセル型〉、油剤皮膜が薄く,電気伝導性が大きいので、湿気に弱い弱点があります。即ち、NC旋盤やマシニングセンタなど機械内部に液が侵入する可能性のある機械に使用すると、機械内部に侵入した水分が蒸発し、機械内部が高湿度の状態になり、腐食が進行すると共に、摺動面のように金属同士が接触している部分に侵入すると、電気的な腐食が生じやすくなります。
機械内部の腐敗を防ぎ、機械寿命を延長するには、ミセル型の油剤をお薦めします。下に、油分を含むミセル型とクリアータイプの防錆・防食試験の結果を示します。
試験方法
検体をビーカーに入れ、サンドペーパーでよく磨いたFC25のテストピースを浸漬後引き上げて、温度37℃湿度90%の恒温恒湿室に入れ、発錆、腐食が生じるまでの期間を観察し、1週間後に写真撮影を行った。
判断基準
機械内部に使用液が浸入する機械に、腐食(孔食)の進行の早い油剤を使用すると、機械内部でも下の写真と同様の現象が生じ、機械寿命が短くなる心配があります。
| 試 験 結 果 | |||
|---|---|---|---|
![]() |
![]() |
||
| 機械: | NC旋盤 | 機械: | NC旋盤 |
| 油剤: | 某社クリアータイプ油剤 | 油剤: | マイティークールSE1 |
| 油剤タイプ: | ノンミセル型 | 油剤タイプ: | ミセル型 |
| 濃度: | 約12倍 | 濃度: | 約15倍 |
| 使用期間: | 約1年間 | 使用期間: | 約1年間 |
| 発錆状況: | 2日目に発錆 | 発錆状況: | 一週間発錆なし |
水系切削油剤の防腐対策
どこのユーザーの機械タンクにもバクテリア・カビは存在しています。下の写真は、あるユーザーの切削油剤使用液から検出されたバクテリア・カビであります。
![]() |
![]() |
|
| a) 好気性および通性嫌気性バクテリアのコロニー (タイショーテクノス製ビオスタンプS) |
b) 大きくていびつなコロニーがカビ、小さくて円形のコロニーが酵母 (タイショーテクノス製ビオスタンプF) |
水系切削油剤は腐敗すると全ての性能が低下します。腐敗による弊害を次に示します。
(1)潤滑性能が低下するため精度・工具寿命が低下する。
(2)防錆性が低下するため製品や機械に錆が生じ、機械内部に液が侵入すれば機械内部が腐食し、機械寿命が低下する。
(3)悪臭が発生し職場環境が悪化する。
(4)腐敗液が傷口に入れば化膿、目に入れば充血、その他の疾病の可能性が生じる。
(5)カビの繁殖によりスライムが発生し、ノズルや配管の詰まりが生じる。
などであります。
私達の身の回りには種々のバクテリア・カビが存在していて、水系切削油剤では大腸菌、緑膿菌、黄色ぶどう状菌などが検出されており、カビでは糸状菌が検出されています。これらの菌が健康障害を起こさないという保証はどこにもありません。
バクテリアやカビは、突然変異を起こしやすく、人に危害を加える形に変異します。どこにでも存在する大腸菌がO−157という恐ろしい病原菌に変異したことは周知の通りであります。鳥インフルエンザのウイルスが人から人へとうつるウイルスに突然変異しないか心配されていますが、このようなことが切削油剤の使用液で起こらないとは断言できません。腐敗している液が傷口に接触して化膿したり、目に入って充血したりするのは良く起こっていることであります。
今後ユーザーでは防腐対策が重要になってくると思われます。
水系切削油剤の環境・安全対策
資料「水系切削油剤の選定・管理とリスクアセスメントについて」をご覧ください。